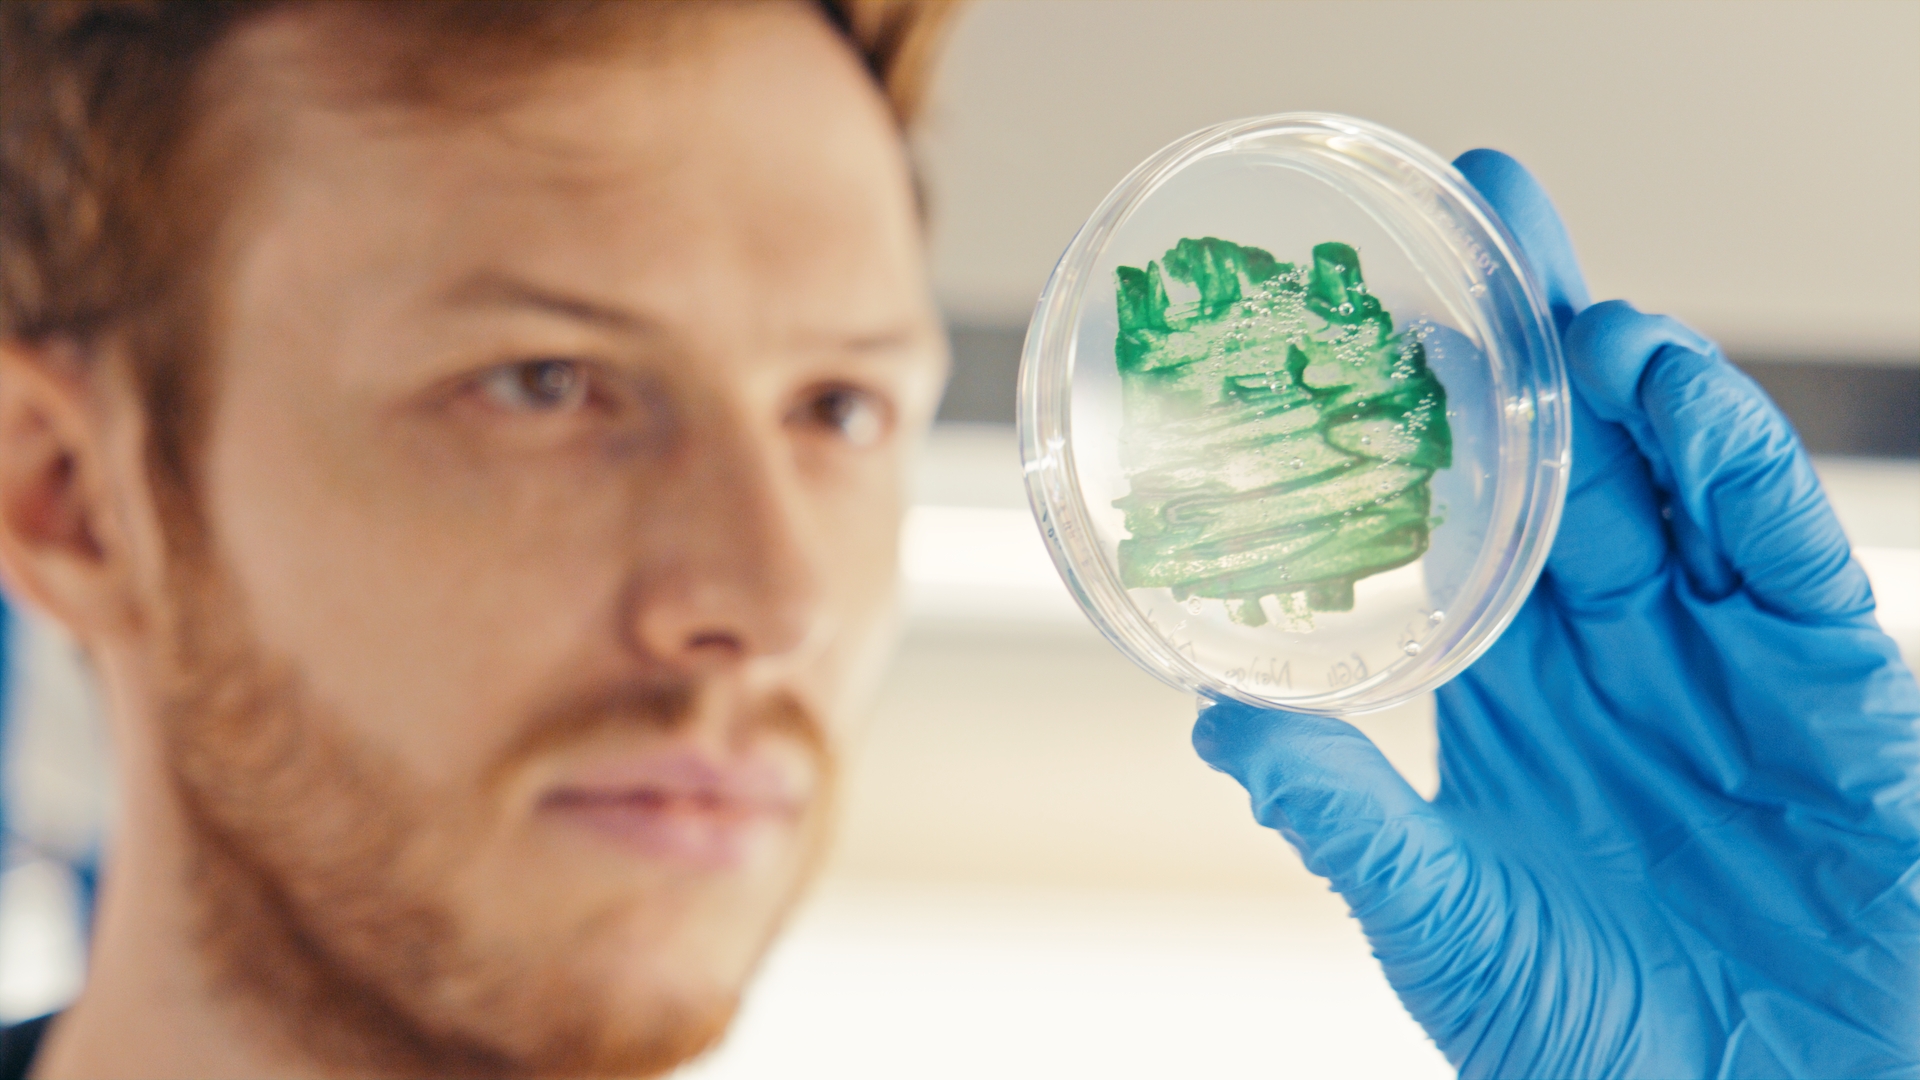

Willkommen bei MINT me!
Dein Portal für spannende Einblicke in die faszinierende Welt der MINT-Berufe – Mathematik, Informatik, Naturwissenschaften und Technik – und die grenzenlosen Möglichkeiten, die sie Dir bieten!
Hier kannst Du entdecken, was hinter den Berufen steckt, die unsere Zukunft gestalten: von der Entwicklung nachhaltiger Technologien über die Entschlüsselung komplexer wissenschaftlicher Zusammenhänge bis hin zur Gestaltung smarter digitaler Lösungen. MINT ist nicht nur ein Bereich, sondern eine Welt voller Innovation, Kreativität und Perspektiven – und sie wartet darauf, von Dir erkundet zu werden.
Ob Du gerade erst über Deine berufliche Zukunft nachdenkst oder bereits konkrete Interessen hast: Hier findest Du Informationen zu Ausbildungsberufen und Arbeitgebern in der Region, um die Vielfalt und Chancen in den MINT-Bereichen regional zu entdecken.
Finde mit Hilfe der Videos und weiteren Unterseiten heraus, was MINT für Dich bedeutet und starte jetzt Dein Abenteuer in die Welt von morgen!